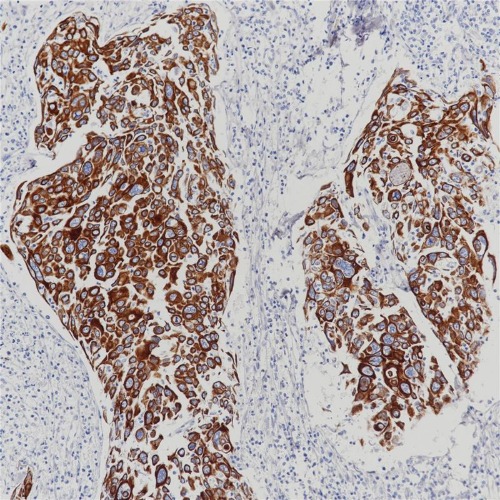

Cytokeratin (HMW) Rabbit Monoclonal Antibody Cocktail(ARB939/ARB933)
CAT.NO. : ARB6882
RMB Please choose
RMB Please choose
Size:
Trail, Bulk size or Custom requests Please contact us
*产品价格可能会有所调整,请以品牌方官网实时更新的价格为准,以确保准确性。
Background
In normal tissues, cytokeratin (high molecular weight) is mainly expressed in normal squamous epithelium, ductal epithelium and other laminated epithelium. Positive expression was found in lung squamous cell carcinoma, breast cancer, pancreatic cancer, cholangiocarcinoma and bladder transitional cell carcinoma. Anti-cytokeratin, high molecular weight is capable of recognizing all basic keratins; therefore, it is a broadly reactive antibody staining most epithelia and their neoplasms. Members of the acidic and basic subfamilies are found together in pairs. Since each epithelium contains at least one acidic and one basic keratin, this antibody is used to observe the distribution of keratin-containing cells in normal epithelia and to identify neoplasms derived from such epithelium.
Application
|
Application |
Dilution Ratio |
|
IHC-P |
1:100-1:200 |
Overview
|
Purity |
ProA affinity purified IgG |
|
Form |
Liquid |
|
Species Cross-reactivity |
Human |
|
Applications |
IHC-P |
|
Storage Buffer |
PBS 59%, Sodium azide 0.01%, Glycerol 40%, BSA 0.05% |
|
Subcellular location |
Cytoplasm |
|
Recommended method |
Heat induced epitope retrieval with Tris-EDTA buffer |
|
Immunogen |
Synthetic peptide corresponding to residues within aa200-300 of Cytokeratin 1 was used as an immunogen. Synthetic peptide according to the aa490-590 (Cterminal) of Cytokeratin 5 was used as an immunogen. |
|
Storage Buffer |
PBS 59%, Sodium azide 0.01%, Glycerol 40%, BSA 0.05% |
Data
Immunohistochemical staining of human cervical squamous cell carcinoma tissue using Cytokeratin (HMW) Rabbit Monoclonal Antibody Cocktail(ARB939/ARB933)
Storage
Store at 4°C short term. For long term storage, store at -20°C, avoiding freeze/thaw cycles.
Research Use Only
For Research Use Only. Not for use in diagnostic procedures.
New Products
